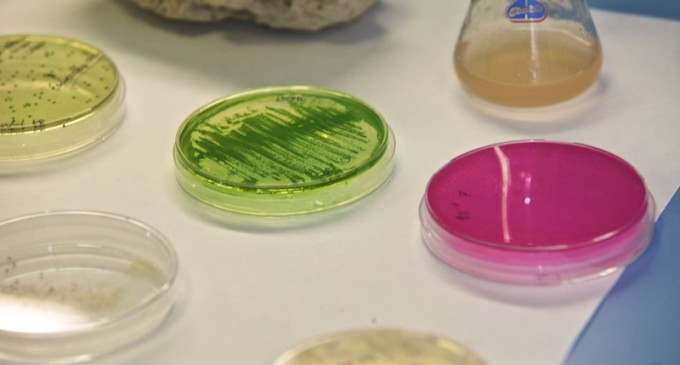

Del Domingo, 12 de Abril de 2026 al Martes, 12 de Mayo de 2026
RANKING
La Universidad de Alicante, entre las mejores del mundo en Química
La Universidad de Alicante (UA) se ha situado por vez primera entre las 200 mejores universidades del mundo en materia de Química, según el Academic Ranking of World Universities (ARWU), más conocido como ranking de Shanghái. Este reconocimiento “pone en valor la intensa labor investigadora y docente” desarrollada por los departamentos de Química Inorgánica, Química Orgánica y Química Física de la UA, según explican desde la institución académica.
Las investigaciones que se realizan en la UA abarcan campos como los nanomateriales y los nuevos materiales, catálisis, electroquímica y espectroscopía, investigación aplicada en síntesis de nuevos compuestos y fármacos, adhesivos y análisis de alimentos. En los grupos de investigación implicados trabajan más de 150 personas entre profesores, doctores, estudiantes de doctorado y personal técnico.
“El alto prestigio de nuestros investigadores viene avalado por los premios internacionales, numerosos proyectos de investigación que se tienen con otras universidades extranjeras, la participación en comités científicos internacionales o el alto impacto de las publicaciones firmadas por los investigadores de la UA”, explica el director del Secretariado de Investigación de la UA, Enrique Herrero.
Elaborado por la Universidad de Jiao Tong de China, el ranking de Shanghái 2014 ha comparado 20.000 centros educativos de todo el mundo. Para elaborar el listado, toma en consideración indicadores como el número de premios Nobel y medallas Fields obtenidos por cada institución, investigadores altamente citados y artículos publicados en Nature o Science durante los últimos diez años. Asimismo, también tiene en cuenta las universidades con una cantidad significativa de artículos indexados por Science Citation Index-Expanded (SCIE) y Social Science Citation Index (SSCI).






















Normas de participación
Esta es la opinión de los lectores, no la de este medio.
Nos reservamos el derecho a eliminar los comentarios inapropiados.
La participación implica que ha leído y acepta las Normas de Participación y Política de Privacidad
Normas de Participación
Política de privacidad
Por seguridad guardamos tu IP
216.73.216.245